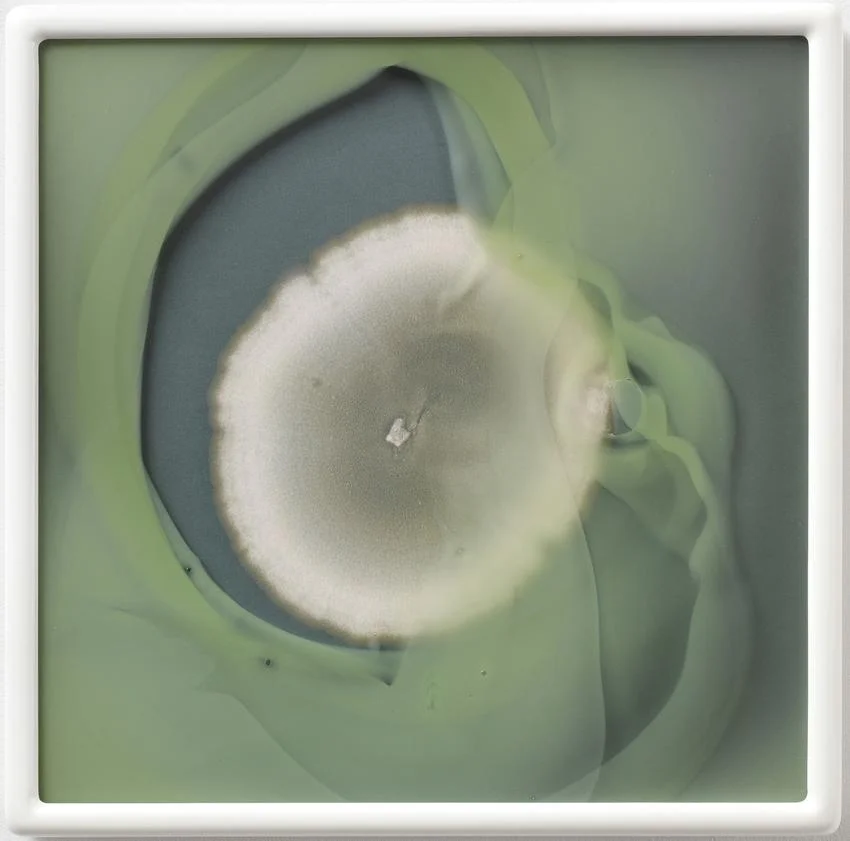

© Dove Allouche, Alternaria Alternata R 20 (MA) #42, 2016
Peter Freeman, Inc. 140 Grand Street, NY 10013
Tel: 212.966.5154
E: info@peterfreemaninc.com
Hours: Tuesday - Saturday 10 - 6pm

MUSÉE 29 – EVOLUTION
Evolution explores the concepts of progress, transformation, growth, and advancement in an age when images are taking a dramatic shift in the role they play in our lives.
© Dove Allouche, Alternaria Alternata R 20 (MA) #42, 2016
Peter Freeman, Inc. 140 Grand Street, NY 10013
Tel: 212.966.5154
E: info@peterfreemaninc.com
Hours: Tuesday - Saturday 10 - 6pm